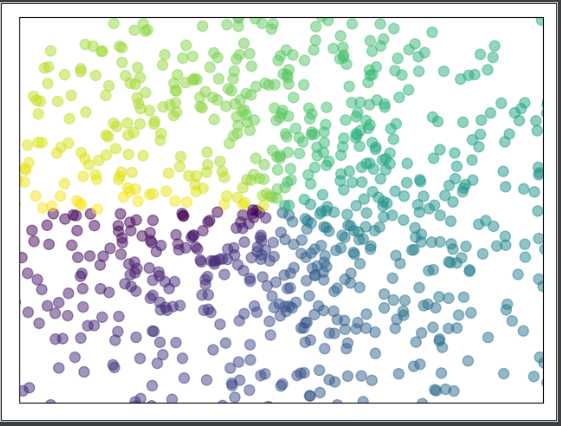

Python进阶学习---matplotlib的使用
基础用法
使用import导入模块matplotlib.pyplot,并简写成plt;使用import导入模块numpy,并简写成np
import matplotlib.pyplot as plt import numpy as np
使用np.linspace定义x:范围是(-1,1);个数是100,仿真一维数据(x,y)表示曲线1
x=np.linspace(-1,1,100)
y=2*x+1
使用plt.figure定义一个图像窗口,使用plt.plot画(x,y)曲线,使用plt.show显示图像
plt.figure()
plt.plot(x,y)
plt.show()

figure图像
如上所述,画出一个基本图像
import matplotlib.pyplot as plt import numpy as np x=np.linspace(-3,3,50) y1=2*x+1 y2=x**2 plt.figure() plt.plot(x,y1) plt.show()
得到下图:

使用plt.figure定义一个图像窗口:标号为3;大小为(8,5),使用plt.plot画(x,y2)曲线,曲线的颜色属性(color)为蓝色;曲线的宽带(linewidth)为5.0;曲线的类型(linestyle)为实线;使用plt.plot画(x,y1)曲线,曲线的颜色属性(color)为红色;曲线的宽带(linewidth)为1.0;曲线的类型(linestyle)为虚线,使用plt.show()显示图像。
plt.figure(num=3,figsize=(8,5)) plt.plot(x,y1,color=‘red‘,linewidth=1.0,linestyle=‘--‘) plt.plot(x,y2,color=‘blue‘,linewidth=5.0,linestyle=‘-‘) plt.show()
得到图像:

设置坐标轴
先建立一个基本图像
import matplotlib.pyplot as plt import numpy as np x = np.linspace(-3, 3, 50) y1 = 2*x + 1 y2 = x**2 plt.figure() plt.plot(x, y2) plt.plot(x, y1, color=‘red‘, linewidth=1.0, linestyle=‘--‘)
plt.show()

使用plt.xlim设置x坐标轴范围:(-1, 2); 使用plt.ylim设置y坐标轴范围:(-2, 3); 使用plt.xlabel设置x坐标轴名称:’I am x’; 使用plt.ylabel设置y坐标轴名称:’I am y’;
plt.xlim((-1, 2)) plt.ylim((-2, 3)) plt.xlabel(‘I am x‘) plt.ylabel(‘I am y‘)

使用np.linspace定义范围以及个数:范围是(-1,2);个数是5. 使用print打印出新定义的范围. 使用plt.xticks设置x轴刻度:范围是(-1,2);个数是5.
new_ticks = np.linspace(-1, 2, 5) print(new_ticks) #[-1. -0.25 0.5 1.25 2. ] plt.xticks(new_ticks)
使用plt.yticks设置y轴刻度以及名称:刻度为[-2, -1.8, -1, 1.22, 3];对应刻度的名称为[‘really bad’,’bad’,’normal’,’good’, ‘really good’]. 使用plt.show显示图像.
plt.yticks([-2, -1.8, -1, 1.22, 3],[r‘$really\ bad$‘, r‘$bad$‘, r‘$normal$‘, r‘$good$‘, r‘$really\ good$‘]) plt.show()

使用plt.gca获取当前坐标轴信息. 使用.spines设置边框:右侧边框;使用.set_color设置边框颜色:默认白色; 使用.spines设置边框:上边框;使用.set_color设置边框颜色:默认白色;

使用.xaxis.set_ticks_position设置x坐标刻度数字或名称的位置:bottom.(所有位置:top,bottom,both,default,none)
再使用.spines设置边框:x轴;使用.set_position设置边框位置:y=0的位置;(位置所有属性:outward,axes,data)

使用.yaxis.set_ticks_position设置y坐标刻度数字或名称的位置:left.(所有位置:left,right,both,default,none)
使用.spines设置边框:y轴;使用.set_position设置边框位置:x=0的位置;(位置所有属性:outward,axes,data) 使用plt.show显示图像.

legend图例
import matplotlib.pyplot as plt import numpy as np x = np.linspace(-3, 3, 50) y1 = 2*x + 1 y2 = x**2 plt.figure() #set x limits plt.xlim((-1, 2)) plt.ylim((-2, 3)) # set new sticks new_sticks = np.linspace(-1, 2, 5) plt.xticks(new_sticks) # set tick labels plt.yticks([-2, -1.8, -1, 1.22, 3], [r‘$really\ bad$‘, r‘$bad$‘, r‘$normal$‘, r‘$good$‘, r‘$really\ good$‘])
本节中我们将对图中的两条线绘制图例,首先我们设置两条线的类型等信息(蓝色实线与红色虚线).
# set line syles l1, = plt.plot(x, y1, label=‘linear line‘) l2, = plt.plot(x, y2, color=‘red‘, linewidth=1.0, linestyle=‘--‘, label=‘square line‘)
legend将要显示的信息来自于上面代码中的 label. 所以我们只需要简单写下一下代码, plt 就能自动的为我们添加图例.
plt.legend(loc=‘upper right‘)
参数 loc=‘upper right‘ 表示图例将添加在图中的右上角.

如果我们想单独修改之前的 label 信息, 给不同类型的线条设置图例信息. 我们可以在 plt.legend 输入更多参数. 如果以下面这种形式添加 legend, 我们需要确保, 在上面的代码 plt.plot(x, y2, label=‘linear line‘) 和 plt.plot(x, y1, label=‘square line‘) 中有用变量 l1 和 l2 分别存储起来. 而且需要注意的是 l1, l2,要以逗号结尾, 因为plt.plot() 返回的是一个列表.
plt.legend(handles=[l1, l2], labels=[‘up‘, ‘down‘], loc=‘best‘)
这样我们就能分别重新设置线条对应的 label 了.
最后我们得到带有图例信息的图片.

其中’loc’参数有多种,’best’表示自动分配最佳位置,其余的如下:
‘best‘ : 0, ‘upper right‘ : 1, ‘upper left‘ : 2, ‘lower left‘ : 3, ‘lower right‘ : 4, ‘right‘ : 5, ‘center left‘ : 6, ‘center right‘ : 7, ‘lower center‘ : 8, ‘upper center‘ : 9, ‘center‘ : 10,
标注
画出基本图
当图线中某些特殊地方需要标注时,我们可以使用 annotation. matplotlib 中的 annotation 有两种方法, 一种是用 plt 里面的 annotate,一种是直接用 plt 里面的 text 来写标注.
首先,我们在坐标轴中绘制一条直线.
import matplotlib.pyplot as plt import numpy as np x = np.linspace(-3, 3, 50) y = 2*x + 1 plt.figure(num=1, figsize=(8, 5),) plt.plot(x, y,)

移动坐标
然后我们挪动坐标轴的位置.
ax = plt.gca() ax.spines[‘right‘].set_color(‘none‘) ax.spines[‘top‘].set_color(‘none‘) ax.spines[‘top‘].set_color(‘none‘) ax.xaxis.set_ticks_position(‘bottom‘) ax.spines[‘bottom‘].set_position((‘data‘, 0)) ax.yaxis.set_ticks_position(‘left‘) ax.spines[‘left‘].set_position((‘data‘, 0))

然后标注出点(x0, y0)的位置信息. 用plt.plot([x0, x0,], [0, y0,], ‘k--‘, linewidth=2.5) 画出一条垂直于x轴的虚线.
x0 = 1 y0 = 2*x0 + 1 plt.plot([x0, x0,], [0, y0,], ‘k--‘, linewidth=2.5) # set dot styles plt.scatter([x0, ], [y0, ], s=50, color=‘b‘)

添加注释annotate
接下来我们就对(x0, y0)这个点进行标注.
plt.annotate(r‘$2x+1=%s$‘ % y0, xy=(x0, y0), xycoords=‘data‘, xytext=(+30, -30), textcoords=‘offset points‘, fontsize=16, arrowprops=dict(arrowstyle=‘->‘, connectionstyle="arc3,rad=.2"))
其中参数xycoords=‘data‘ 是说基于数据的值来选位置, xytext=(+30, -30) 和 textcoords=‘offset points‘ 对于标注位置的描述 和 xy 偏差值, arrowprops是对图中箭头类型的一些设置.

添加注释text
plt.text(-3.7, 3, r‘$This\ is\ the\ some\ text. \mu\ \sigma_i\ \alpha_t$‘, fontdict={‘size‘: 16, ‘color‘: ‘r‘})
其中-3.7, 3,是选取text的位置, 空格需要用到转字符\ ,fontdict设置文本字体

tick能见度
生成图形
当图片中的内容较多,相互遮盖时,我们可以通过设置相关内容的透明度来使图片更易于观察,也即是通过本节中的bbox参数设置来调节图像信息.
首先参考之前的例子, 我们先绘制图像基本信息:
import matplotlib.pyplot as plt import numpy as np x = np.linspace(-3, 3, 50) y = 0.1*x plt.figure() # 在 plt 2.0.2 或更高的版本中, 设置 zorder 给 plot 在 z 轴方向排序 plt.plot(x, y, linewidth=10, zorder=1) plt.ylim(-2, 2) ax = plt.gca() ax.spines[‘right‘].set_color(‘none‘) ax.spines[‘top‘].set_color(‘none‘) ax.spines[‘top‘].set_color(‘none‘) ax.xaxis.set_ticks_position(‘bottom‘) ax.spines[‘bottom‘].set_position((‘data‘, 0)) ax.yaxis.set_ticks_position(‘left‘) ax.spines[‘left‘].set_position((‘data‘, 0))

调整坐标
然后对被遮挡的图像调节相关透明度,本例中设置 x轴 和 y轴 的刻度数字进行透明度设置
for label in ax.get_xticklabels() + ax.get_yticklabels(): label.set_fontsize(12) # 在 plt 2.0.2 或更高的版本中, 设置 zorder 给 plot 在 z 轴方向排序 label.set_bbox(dict(facecolor=‘white‘, edgecolor=‘None‘, alpha=0.7, zorder=2)) plt.show()
其中label.set_fontsize(12)重新调节字体大小,bbox设置目的内容的透明度相关参,facecolor调节 box 前景色,edgecolor 设置边框, 本处设置边框为无,alpha设置透明度. 最终结果如下:

scatter散点图
首先,先引入matplotlib.pyplot简写成plt,再引入模块numpy用来产生一些随机数据。生成1024个呈标准正态分布的二维数据组(平均数是0,方差是1)作为一个数据集,并图像化这个数据集。每一个点的颜色值用T来表示:
import matplotlib.pyplot as plt import numpy as np n = 1024 # data size X = np.random.normal(0, 1, n) # 每一个点的X值 Y = np.random.normal(0, 1, n) # 每一个点的Y值 T = np.arctan2(Y,X) # for color value
数据集生成完毕,现在用来scatter来plot这个点集,鼠标点上去,可以看到这个函数的各个parameter的描述,如下图:

输入X和Y作为location,size=75,颜色为T,color map用默认值,透明度alpha为50%,X轴显示范围为(-1.5,1.5),并用xtick()函数来隐藏x坐标轴,y轴同理:
plt.scatter(X, Y, s=75, c=T, alpha=.5) plt.xlim(-1.5, 1.5) plt.xticks(()) # ignore xticks plt.ylim(-1.5, 1.5) plt.yticks(()) # ignore yticks plt.show()
效果如下图:
bar直方图
先上效果图:

生成基本图形
向上和向下分别生成12个数据,X为0~11的整数,Y是相应的均匀分布的随机数据。使用的函数是plt.bar,参数是X和Y:
import matplotlib.pyplot as plt import numpy as np n = 12 X = np.arange(n) Y1 = (1 - X / float(n)) * np.random.uniform(0.5, 1.0, n) Y2 = (1 - X / float(n)) * np.random.uniform(0.5, 1.0, n) plt.bar(X, +Y1) plt.bar(X, -Y2) plt.xlim(-.5, n) plt.xticks(()) plt.ylim(-1.25, 1.25) plt.yticks(()) plt.show()
生成基本框架图像:

加颜色和数据
下面我们就颜色和数值进行优化。用facecolor设置主体颜色,edgecolor设置边框颜色为白色:
plt.bar(X, +Y1, facecolor=‘#9999ff‘, edgecolor=‘white‘) plt.bar(X, -Y2, facecolor=‘#ff9999‘, edgecolor=‘white‘)
效果如下:

接下来我们用函数plt.text分别在柱体上方和下方加上数值,用%.2f保留2位小数,横向居中对齐ha=‘center‘,纵向底部(顶部)对齐va=‘bottom‘
for x,y in zip(X,Y1): plt.text(x,y,‘%.2f‘%y,ha=‘center‘,va=‘bottom‘) for x,y in zip(X,Y2): plt.text(x,-y,‘%.2f‘%y,ha=‘center‘,va=‘top‘)
最终效果如下图:

contours等高线图
画等高线
数据集即三维点 (x,y) 和对应的高度值,共有256个点。高度值使用一个 height function f(x,y) 生成。 x, y 分别是在区间 [-3,3] 中均匀分布的256个值,并用meshgrid在二维平面中将每一个x和每一个y分别对应起来,编织成栅格:
import matplotlib.pyplot as plt import numpy as np def f(x,y): # the height function return (1 - x / 2 + x**5 + y**3) * np.exp(-x**2 -y**2) n = 256 x = np.linspace(-3, 3, n) y = np.linspace(-3, 3, n) X,Y = np.meshgrid(x, y)
接下来进行颜色填充。使用函数plt.contourf把颜色加进去,位置参数分别为:X, Y, f(X,Y)。透明度0.75,并将 f(X,Y) 的值对应到color map的暖色组中寻找对应颜色。
# use plt.contourf to filling contours # X, Y and value for (X,Y) point plt.contourf(X, Y, f(X, Y), 8, alpha=.75, cmap=plt.cm.hot)
接下来进行等高线绘制。使用plt.contour函数划线。位置参数为:X, Y, f(X,Y)。颜色选黑色,线条宽度选0.5。现在的结果如下图所示,只有颜色和线条,还没有数值Label:
# use plt.contour to add contour lines C = plt.contour(X, Y, f(X, Y), 8, colors=‘black‘, linewidth=.5)

添加高度数字
其中,8代表等高线的密集程度,这里被分为10个部分。如果是0,则图像被一分为二。
最后加入Label,inline控制是否将Label画在线里面,字体大小为10。并将坐标轴隐藏:
plt.clabel(C, inline=True, fontsize=10)
plt.xticks(())
plt.yticks(())

3D图
本节效果图:

首先在进行3D plot时除了导入matplotlib,还要额外添加一个模块,即Axes 3D 3D坐标轴显示:
import numpy as np import matplotlib.pyplot as plt from mpl_toolkits.mplot3d import Axes3D
之后要先定义一个图像窗口,在窗口上添加3D坐标轴:
fig = plt.figure() ax = Axes3D(fig) plt.show()
显示效果如下:

接下来给进X和Y值,并将X和Y编织成栅格。每一个(X,Y)点对应的高度值我们用下面这个函数来进行计算:
X=np.arange(-4,4,0.25) Y=np.arange(-4,4,0.25) X,Y=np.meshgrid(X,Y) R=np.sqrt(X**2+Y**2) Z=np.sin(R)
做出一个三维曲面,并将一个colormap rainbow填充颜色,之后将三维图像投影到XY平面上做一个等高线图。plot3D 图像:
ax.plot_surface(X,Y,Z,rstride=1,cstride=1,cmap=plt.get_cmap(‘rainbow‘))
其中,rstride和cstride分别代表row和column的跨度。
下图为跨度为1的效果:

下图为跨度为5的效果:

下面添加XY平面的等高线:
ax.contour(X,Y,Z,zdir=‘z‘,offset=-1,cmap=plt.get_cmap(‘rainbow‘))
如果zdir选择了X,那么效果将会是对于XZ平面的投影,效果如下:

最终效果图入下:

suplot
Subplot多合一显示
均匀图中图
matplotlib 是可以组合许多的小图, 放在一张大图里面显示的. 使用到的方法叫作 subplot.
使用import导入matplotlib.pyplot模块, 并简写成plt. 使用plt.figure创建一个图像窗口.
import matplotlib.pyplot as plt plt.figure()
使用plt.subplot来创建小图. plt.subplot(2,2,1)表示将整个图像窗口分为2行2列, 当前位置为1. 使用plt.plot([0,1],[0,1])在第1个位置创建一个小图.
plt.subplot(2,2,1)
plt.plot([0,1],[0,1])
plt.subplot(2,2,2)表示将整个图像窗口分为2行2列, 当前位置为2. 使用plt.plot([0,1],[0,2])在第2个位置创建一个小图.
plt.subplot(2,2,2)
plt.plot([0,1],[0,2])
plt.subplot(2,2,3)表示将整个图像窗口分为2行2列,当前位置为3. plt.subplot(2,2,3)可以简写成plt.subplot(223), matplotlib同样可以识别. 使用plt.plot([0,1],[0,3])在第3个位置创建一个小图.
plt.subplot(223)
plt.plot([0,1],[0,3])
plt.subplot(224)表示将整个图像窗口分为2行2列, 当前位置为4. 使用plt.plot([0,1],[0,4])在第4个位置创建一个小图.
plt.subplot(224) plt.plot([0,1],[0,4]) plt.show() # 展示

不均匀图中图
如果希望展示的小图的大小不相同, 应该怎么做呢? 以上面的4个小图为例, 如果把第1个小图放到第一行, 而剩下的3个小图都放到第二行.
使用plt.subplot(2,1,1)将整个图像窗口分为2行1列, 当前位置为1. 使用plt.plot([0,1],[0,1])在第1个位置创建一个小图.
plt.subplot(2,1,1)
plt.plot([0,1],[0,1])
使用plt.subplot(2,3,4)将整个图像窗口分为2行3列, 当前位置为4. 使用plt.plot([0,1],[0,2])在第4个位置创建一个小图.
plt.subplot(2,3,4)
plt.plot([0,1],[0,2])
这里需要解释一下为什么第4个位置放第2个小图. 上一步中使用plt.subplot(2,1,1)将整个图像窗口分为2行1列, 第1个小图占用了第1个位置, 也就是整个第1行. 这一步中使用plt.subplot(2,3,4)将整个图像窗口分为2行3列, 于是整个图像窗口的第1行就变成了3列, 也就是成了3个位置, 于是第2行的第1个位置是整个图像窗口的第4个位置.
使用plt.subplot(235)将整个图像窗口分为2行3列,当前位置为5. 使用plt.plot([0,1],[0,3])在第5个位置创建一个小图. 同上, 再创建plt.subplot(236).
plt.subplot(235) plt.plot([0,1],[0,3]) plt.subplot(236) plt.plot([0,1],[0,4]) plt.show() # 展示

动态图
定义方程
使用matplotlib做动画也是可以的,我们使用其中一种方式,function animation来说说, 具体可参考matplotlib animation api。首先,我们做一些准备工作:
from matplotlib import pyplot as plt from matplotlib import animation import numpy as np fig, ax = plt.subplots()
我们的数据是一个0~2π内的正弦曲线:
x = np.arange(0, 2*np.pi, 0.01)
line, = ax.plot(x, np.sin(x))

接着,构造自定义动画函数animate,用来更新每一帧上各个x对应的y坐标值,参数表示第i帧:
def animate(i): line.set_ydata(np.sin(x + i/10.0)) return line,
然后,构造开始帧函数init:
def init(): line.set_ydata(np.sin(x)) return line,
参数设置
接下来,我们调用FuncAnimation函数生成动画。参数说明:
fig进行动画绘制的figurefunc自定义动画函数,即传入刚定义的函数animateframes动画长度,一次循环包含的帧数init_func自定义开始帧,即传入刚定义的函数initinterval更新频率,以ms计blit选择更新所有点,还是仅更新产生变化的点。应选择True,但mac用户请选择False,否则无法显示动画
ani = animation.FuncAnimation(fig=fig, func=animate, frames=100, init_func=init, interval=20, blit=False)
原文:https://www.cnblogs.com/zhuoning/p/11606165.html
